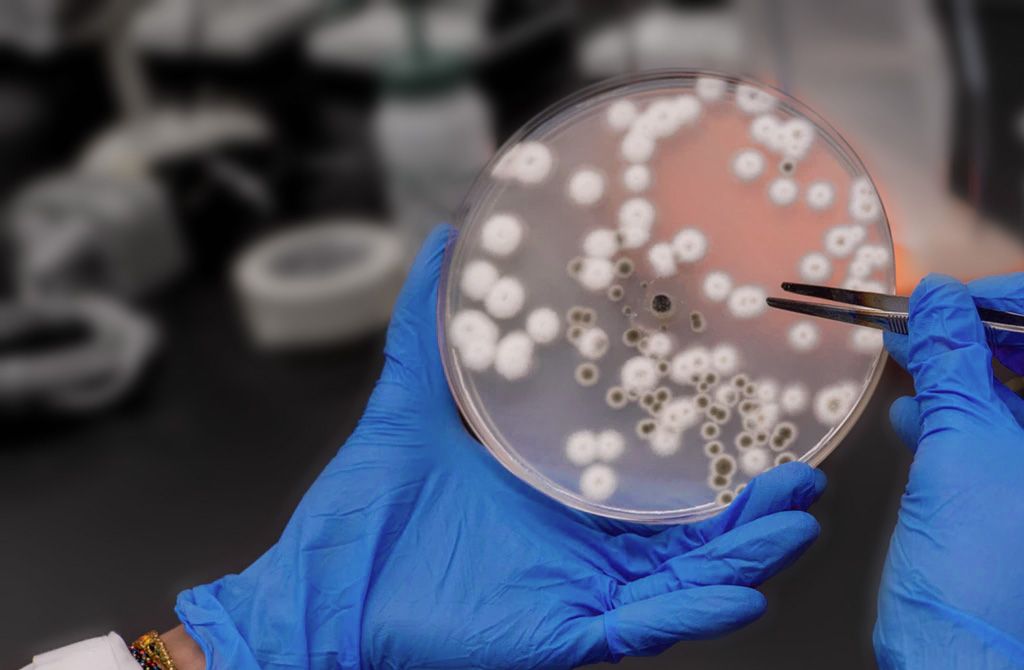

Stomatology Department
Lorem ipsum dolor sit amet, consectetur adipiscing elit, sed do eiusmod tempor incididunt ut labore et dolore magna aliqua. Ut enim ad minim veniam, quis nostrud exercitation ullamco.
We have modern environment, specifically designed to promote your sense of calm and well being.
Lorem ipsum dolor sit amet, consectetur adipiscing elit, sed do eiusmod tempor Maecenas eget ornare diam. Duis aute irure dolor in reprehenderit.
| General Treatment – Tempor incididunt. | Dr. Yoag Nakito Specialist Dentist Lorem ipsum dolor sit amet elit. |
| Orthodontics – Consectetur unt ut. | Dr. Lin Suong Yan Expert Dentist Duis aute irure dolor in reprehenderite. |
Prevention – Fusce et pretiums. | Dr. Yoag Nakito Specialist Dentist Suspendisse cursus felis eu arcu dictum. |
Ambulances
Lorem ipsum dolor sit amet, consectetur adipiscing elit, sed do eiusmod tempor incididunt ut labore et dolore magna aliqua. Ut enim ad minim veniam, quis nostrud exercitation ullamco.
Lorem ipsum dolor sit amet, consectetur adipiscing elit, sed do magna. Ut enim ad minim veniam, quis nostrud exercitation ullamco.